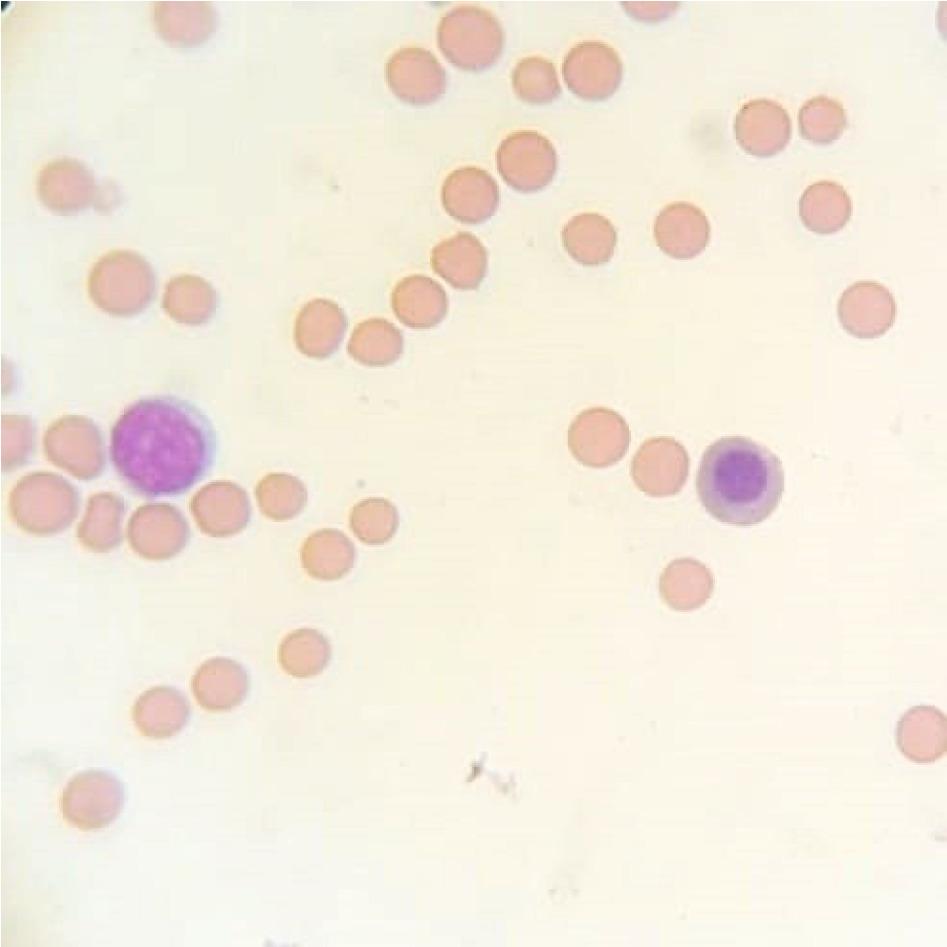

Acrylamide is a compound widely distributed in the environment. Most humans are exposed to different doses of acrylamide from their diet and other sources including inhalation of tobacco smoke (7). Due to the widespread presence of animals in the human environment, pets, and livestock are also susceptible to its negative effects. Therefore, it seems to be necessary to investigate in detail the specific vulnerability of domestic animals to acrylamide toxicity. This compound is naturally formed in food, especially those high in carbohydrates, as best exemplified by potatoes and cereals, or those subjected to heat treatment above 120°C (11, 14). Acrylamide is absorbed into the body through the digestive tract, respiratory system, and skin. Numerous studies have confirmed the harmful activity of this compound indicating its genotoxicity in rats and mice (19). The effect on the body of prolonged acrylamide exposure can be damage to the central nervous system, which is exhibited in neurological signs (21). The effect of acrylamide also manifests in impaired fertility, increased risk of heart diseases, chronic inflammation and, in consequence, increased incidences of atherosclerosis (20).
Many studies have been conducted since the presence of acrylamide in food was discovered and their results indicate the harmfulness of this compound and its involvement in the development of cancer. Despite many studies on animals indicating a relationship between the occurrence of cancer in animals and the presence of acrylamide in the diet, none of the studies conducted on humans clearly demonstrate a direct effect of the compound on the formation of various types of cancer in humans (15, 17). However, the EFSA (European Food Safety Authority) has noted that although the epidemiological associations have not proved this substance to be a human carcinogen, the margins of exposure indicate a concern over neoplastic effects based on animal evidence (6). Studies undeniably indicate a relationship between extensive acrylamide occurrence in the environment and an increase in the incidence of cancer (12). Being a widespread compound in the environment, and therefore one to which exposure is chronic, acrylamide can also affect the processes of erythropoiesis in the bone marrow (18). Studies on workers who had frequent contact with acrylamide showed a clear relationship between the level of acrylamide-haemoglobin adducts and symptoms suggesting damage to the central nervous system (8).
Due to the fact that people are exposed to the effects of low doses of acrylamide throughout their whole lives, and despite the extensive toxicological data on acrylamide, it is reasonable to conduct more research and in-depth analyses on how strong and diverse the impact of this compound on human and animal organisms is, and whether exposure to it could be a more serious threat to human and animal health. Genetic similarities and parallels in the organisms’ reactions to pathological states between humans and pigs determined our choice of experimental animals. The porcine model provides a chance of extrapolation of the results of this study to humans.
The aim of this study was to assess the influence of low and high doses of acrylamide on erythroblastic cell line cytology in porcine bone marrow.
Animals and design of the experiment. The study was performed on 15 female Danish Landrace pigs, eight weeks old, and weighing approximately 20 kg. All animals were kept under standard laboratory conditions, had free access to water and were fed a commercial grain mixture. After seven days of acclimatisation, the pigs were randomly assigned to one of three equal groups (n = 5): a control group (C group) of animals receiving a placebo in the form of an empty gelatine capsule, a low dose group (LD group) of animals receiving capsules of acrylamide with the tolerable daily intake (TDI) (0.5 μg/kg b.w./day) (>99% purity; Sigma-Aldrich, Poland), and a high dose group (HD group) of animals receiving capsules of the same acrylamide with a dose 10 times higher than the TDI (5 μg/kg b.w./day). The lower dose of acrylamide used in the present study is a dose recognised in many countries as the TDI or reference dose for acrylamide and is considered to be safe for humans and animals. To ensure the appropriate dose of acrylamide, all pigs were weighed once a week. Capsules were administered with feed in the morning for 28 days. After this time, all animals were treated with an intramuscular injection of 4 mg/kg b.w. of azaperone (Stresnil, Jansen Pharmaceutica N.V., Belgium) and euthanised after 15 min using a lethal dose of sodium pentobarbital intravenously (Morbital, Biowet Puławy, Poland; 0.6 mL/kg b.w.).
Sample collection. Bone marrow was collected from all animals twice – at the beginning of the experiment (day 0, before the first acrylamide administration), and at the end (day 28 of acrylamide administration). Bone marrow was sampled under local anaesthesia with xylazine hydrochloride (Rompun, Bayer, Germany, 1.5 mg/kg b.w. intramuscularly) and zolazepam with tiletamine (Zoletil, Virbac, France, 2.2 mg/kg b.w. intramuscularly), from the lateral condyle of the femur using Jamshidi bone marrow needles (Synthes, Austria). Bone marrow was collected into two tubes without anticoagulant and used to prepare smears.
Cytological evaluation of bone marrow smears. The bone marrow smears were stained using the May– Grünwald method and evaluated under an Eclipse 80i light microscope (Nikon, Japan) using an SH-96/24D haematological counter (Alchem, Poland). The number of cells by individual type from the erythroblastic cell line was defined in relation to 1,000 of all bone marrow cells, which is a standard method of cytological evaluation of bone marrow.
Statistical analysis. It was performed using the ANOVA test with Statistica 10 software (StatSoft Tibco, USA) and the post-hoc test was the Kruskal–Wallis one. The differences were considered statistically significant at P ≤ 0.05.
The results of the statistical analysis with the ANOVA test on day 0 of the experiment did not show statistically significant differences between the groups (Table 1). The differences in the number of proerythroblasts (proerbl) between the control group and the HD group were statistically significant on day 28 of the experiment (Table 2). In addition, the difference in the cell population size between these two experimental groups was statistically significant at that time. There were no significant differences between the control group and the LD group regarding these cells. Acrylamide at the low dose caused a statistically significant decrease in the population of basophilic erythroblasts (baso erbl). Low and high doses of acrylamide caused a significant drop in the number of polychromatophilic (polyerbl) and acidophilic erythroblasts (orthoerbl). In addition, these differences were statistically significant between both experimental groups. Statistical analysis also showed significant differences in the number of normoblasts (total normo) between both experimental groups and the control group.
The average number of cells from the erythroblastic cell line in relation to 1,000 of all porcine bone marrow cells (mean ± SD) on day 0
| Parameter | Control | LD | HD |
|---|---|---|---|
| PROERBL | 20.6 ± 2.72 | 20.2 ± 2.24 | 21 ± 1.6 |
| BASO ERBL | 25.8 ± 3.76 | 27.2 ± 2.56 | 24.6 ± 3.68 |
| POLY ERBL | 75.8 ± 13.76 | 69.2 ± 9.84 | 78.4 ± 9.52 |
| ORTHO ERBL | 202 ± 15.6 | 196.2 ± 9.36 | 201.2 ± 7.36 |
| TOTAL NORMO | 324.2 ± 29.84 | 312.8 ± 15.76 | 325.2 ± 16.96 |
| PROMEGALOBL | 0 | 0 | 0 |
| BASO MEGALO | 0 | 0 | 0 |
| POLY MEGALO | 0 | 0 | 0 |
| TOTAL MEGALO | 0 | 0 | 0 |
| NORMO/MEGAL | 0 | 0 | 0 |
| PARA ERB | 0.6 ± 0.72 | 0 | 0 |
| TOTAL ERBL | 324.8 ± 29.76 | 312.8 ± 15.76 | 325.2 ± 16.96 |
PROERBL – proerythroblast; BASO ERBL – basophilic erythroblast; POLY ERBL – polychromatic erythroblast; ORTO ERBL – orthochromatic erythroblast; TOTAL NORMO – total number of normocytes; PROMEGALOBL – promegaloblast; BASO MEGALO – basophilic megaloblasts; POLY MEGALO – polychromatic megaloblast; TOTAL MEGALO – total number of megaloblasts; NORMO/MEGALO – normoblasts/megaloblasts; PARA ERB – paraerythroblast; TOTAL ERBL – total number of cells from erythroblastic cell line
The average number of cells from the erythroblastic cell line in relation to 1,000 of all porcine bone marrow cells (mean ± SD) on day 28
| Parameter | Control | LD | HD |
|---|---|---|---|
| PROERBL | 21.2b ± 1.84 | 18.6c ± 2.48 | 26ac ± 6.4 |
| BASO ERBL | 24.4a ± 2.27 | 18.8ac ± 3.76 | 25.8c ± 3.84 |
| POLY ERBL | 70.2ab ± 6.2 | 60.6ac ± 15.12 | 56.6bc ± 7.92 |
| ORTO ERBL | 190ab ± 11.2 | 165ac ± 7.2 | 91.2bc ± 10.96 |
| TOTAL NORMO | 305.8ab ± 14.96 | 263ac ± 14 | 201.8bc ± 11.84 |
| PROMEGALOBL | 0 | 0 | 0 |
| BASO MEGALO | 0 | 0 | 0 |
| POLY MEGALO | 0 | 0 | 0 |
| TOTAL MEGALO | 0 | 0 | 0 |
| NORMO/MEGALO | 0 | 0 | 0 |
| PARA ERBL | 0 | 0 | 0 |
| TOTAL ERBL | 305.8ab ± 14.96 | 263ac ± 14 | 201.8bc ± 11.84 |
Statistically significant differences (P < 0.05) are marked by a – difference between the control and LD groups; b – difference between control and HD groups; c – difference between LD and HD groups. Abbreviations as in Table 1
Fig. 1 shows a Howell–Jolly body in an erythrocyte in the HD group on the 28th day of the experiment. Fig. 2 presents basophilic and normochromatic erythroblasts in the control group on day 0. Figs 3 and 4 illustrate how erythroblast and basophilic erythroblasts appeared in the LD group on the 28th day of the experiment. Lastly, Figs 5 and 6 provide a view of polychromatic erythroblasts and basophilic erythroblasts in the HD group on day 28.
Fig. 1
Representative cytological image of a bone marrow smear stained with the May–Grünwald–Giemsa method showing a Howell– Jolly body in erythrocyte in the HD group on day 28; 1,000×

Fig. 2
Representative cytological image of a bone marrow smear stained with the May–Grünwald–Giemsa method showing basophilic and normochromatic erythroblasts in the control group on day 0; 1,000×

Fig. 3
Representative cytological image of a bone marrow smear stained with the May–Grünwald–Giemsa method showing basophilic erythroblasts in the LD group on day 28; 1,000×
Fig. 4
Representative cytological image of a bone marrow smear stained with the May–Grünwald–Giemsa method showing polychromatic erythroblasts in the LD group on day 28; 1,000×

Fig. 5
Representative cytological image of a bone marrow smear stained with the May–Grünwald–Giemsa method showing polychromatic erythroblasts in the HD group on day 28; 1,000×

Fig. 6
Representative cytological image of a bone marrow smear stained with the May–Grünwald–Giemsa method showing basophilic erythroblasts in the HD group on day 28; 1,000×

Acrylamide toxicity to internal organs is discussed in many studies (2, 4), and others on mice and rats show that medium and high doses are genotoxic (10, 17, 19). Humans and animals are continually exposed to different doses of acrylamide. It is extremely important to determine whether low doses of acrylamide can induce toxic effects on bone marrow and the process of erythropoiesis. Yener (18) in his study on rats proved that even small doses of acrylamide generate bone marrow responses in the erythroblastic cell line visible as micronuclei in polychromatic erythrocytes.
During the present investigation, some significant differences in the number of several types of cells from the erythroblastic system between the control and experimental groups of animals were noted (Table 2). The influence of acrylamide on the total number of erythroblasts was clearly demonstrated in a decrease in the number of erythroblastic cells in both experimental groups. A decrease in the number of basophilic, polychromatophilic and orthochromatic erythroblasts clearly shows that acrylamide suppresses the process of erythropoiesis in porcine bone marrow.
In addition, numerous Howell–Jolly bodies were found in erythrocytes in bone marrow smears, which may indicate significant disorders of two processes – erythropoiesis and haemoglobin synthesis (Fig. 1). Even though these bodies are often present in erythrocytes of healthy animals, they occur in greater numbers of erythrocytes in animals that have been poisoned with substances commonly found in the environment, e.g. bisphenol A (13). Therefore, an important conclusion of this study is that changes in the number of erythroblasts and disturbances in ratios between them in groups receiving low and high doses of acrylamide in comparison to the control group disturb the process of erythropoiesis in porcine bone marrow.
Cicchetti et al. (3) showed that the decrease in the polychromatic erythrocytes/normochromatic erythrocytes ratio was evidence of weakening of erythropoiesis in bone marrow that manifested in a decrease in the number of erythrocyte precursor cells, or erythroblasts. Those findings are consistent with the results obtained by the authors of this publication who also proved that in the group of animals receiving low doses of acrylamide and the group receiving high doses there was a significant decrease in the poly erbl/total normo ratio compared to the ratio in the control group. The study by El-Tohamy and Bayomy (5) showed that damage to rat bone marrow cells as a result of administration of different doses of acrylamide can be reduced by the administration of vitamin E, which in this case has a protective effect on immature bone marrow cells. Similar results were obtained by Lambert et al. (9). Alzahrani (1) indicated that acrylamide exhibits a much weaker effect on bone marrow cells under the influence of L-carnitine, because the modulation of DNA repair by L-carnitine as an alternative mechanism counteracts chromatic aberrations caused by acrylamide. Acrylamide can affect erythropoiesis and erythrocytes not only in bone marrow, but also in peripheral blood. Research conducted by von Stedingk et al. (16) indicated the presence of products of acrylamide and haemoglobin adducts in maternal and umbilical cord blood. They demonstrated that the placenta inconsiderably protects the foetus from the acrylamide exposure, and higher levels of those adducts in umbilical cord blood may reflect the gestational age-related changes of the cord blood Hb composition and acrylamide exposure to the foetus during the third trimester.
Mitigation of the negative effects of acrylamide is an area for future research. In this study, the porcine model was used, which is the closest to the human one regarding physiological and genetic similarities. Besides demonstrating that both low and high doses of acrylamide generate a significant decrease in the number of polychromatophilic erythroblasts in porcine bone marrow smears, the results obtained in this experiment may also be useful as reference material for potential acrylamide intoxication therapy studies in human medicine.